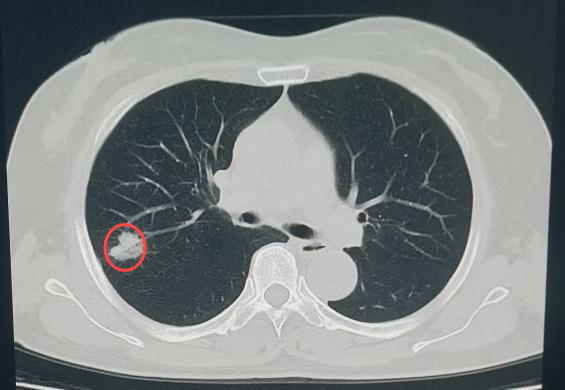

在健康防护的战场上,“尽早发现、尽早治疗”是守护生命的关键防线。涪陵区人民医院放射影像科依托先进技术,积极开展肺结节早癌筛查工作,为民众健康筑牢坚实屏障。
今年3月,王女士因鼻部出血不止,前往涪陵区人民医院耳鼻喉科住院治疗。在术前检查环节,医生为其开具了胸部CT检查单。正是这一常规检查,成为了发现潜在健康危机的转折点。
放射影像科在诊断过程中,借助AI肺结节筛查软件,敏锐捕捉到王女士右侧肺叶存在一个大小约17×22mm的部分实性结节。不仅如此,系统还迅速调取了她2023年在该院体检时的影像资料。影像科医生仔细比对后发现,虽然2023年王女士右肺叶的结节已存在且大小无明显变化,但结节的质地从磨玻璃样转变为少许实性的混合磨玻璃样,边界进一步清晰,边缘还出现了浅分叶及短毛刺等典型的恶性征象。与此同时,AI筛查软件也发出警示,将该结节的危险程度判定为“高危”。即便王女士自述并无任何呼吸系统症状,凭借专业的判断,影像科还是高度怀疑该结节存在肿瘤性病变的可能。

(2023年结节影)
(2025年结节影)
随后,心胸外科医生对王女士的病情进行了会诊,王女士也在完成耳鼻咽喉科的治疗后,欣然接受了医生的建议,果断选择胸腔镜下结节切除术。术后病理检查结果证实,病灶为早期浸润型腺癌。幸运的是,由于发现及时,王女士术后恢复良好,顺利出院。劫后余生的王女士,对医院的感激之情溢于言表,她感慨道:“真的太感谢医院了,不仅治好了我的病,更让我见识到现代影像诊断在AI智能加持下的强大力量,是它帮我及时发现了隐藏的‘健康杀手’!”

(手术后)
这份精准高效的诊断背后,是涪陵区人民医院放射影像科在技术创新上的不懈努力。自2022年引入肺结节AI智能筛查软件以来,科室的肺结节早癌筛查工作开启了全新篇章。该软件以16排以上螺旋CT低剂量薄层扫描生成的亚毫米级图像为基础,借助人工智能技术,能够对肺部实性、磨玻璃结节等进行精准自动筛查,准确率超90%。此外,它还具备强大的影像对比分析功能,可对同一患者的历史随访影像进行细致比对,精准提示结节的发展变化、预后趋势,并科学预测结节的危险程度。这一技术的应用,不仅大幅减轻了医生的工作负担,更让早癌结节筛查与诊断的准确性实现了质的飞跃。
如今,涪陵区人民医院放射影像科已拥有一支技术精湛、设备先进的医疗团队。岛津直接数字化X线成像系统(DR)、数字动态平板DR多功能机、联影40排及飞利浦16排、64排螺旋CT、联影UMR-560 1.5T磁共振、岛津中板DSA(血管机)等多台大中型检查设备一应俱全。同时,科室还引入了肺结节AI筛查、冠状动脉及头颈血管CTA智能诊断等多套AI诊断软件,全方位满足全身各系统疾病的检查与诊断需求。更贴心的是,科室始终秉持“以患者为中心”的服务理念,坚持全天候接诊,全年无休,只为在第一时间为患者提供专业、高效的医疗服务。
健康无小事,早筛是关键。若您有相关检查需求,欢迎致电咨询,涪陵区人民医院放射影像科将以专业的技术、温暖的服务,为您的健康保驾护航!